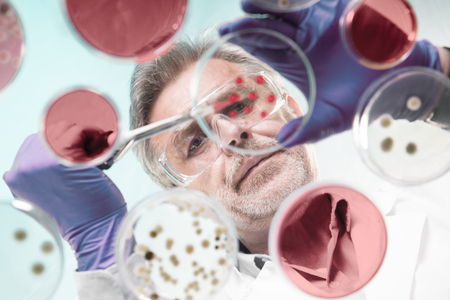

写真素材 - Focused senior life science professional grafting bacteria in the pettri dishes. Lens focus on researchers pace. Through the glass view.
作品情報
Focused senior life science professional grafting bacteria in the pettri dishes. Lens focus on researchers pace. Through the glass view.
- ID:84640863
- 作品種別:写真
- 作者名:Matej Kastelic
キーワード
- DNA
- analyze
- bacteria
- bio
- biological
- biology
- blue
- cell
- clinical
- close-up
- colony
- culture
- detail
- dish
- drop
- experiment
- fluid
- fungi
- genetics
- glass
- glove
- goggles
- graft
- grow
- healthcare
- laboratory
- life
- liquid
- macro
- man
- medical
- medicine
- micro
- organism
- person
- petri
- pharmacy
- pipette
- plate
- research
- researcher
- sample
- science
- scientific
- scientist
- senior
- serum
- technology
- test
- virus
類似作品
Physicist condu...
Man, scientist ...
Dish.
A doctor analyz...
Senior male sci...
Focused senior ...
Senior scientis...
Scientist in a ...
Focused Scienti...
shot of a matur...
shot of a matur...
Mature woman, s...
Team Asian scie...
In a bustling f...
An elderly Cauc...
Medical profess...
Senior professo...
Senior chemistr...
One down and a ...
Microscope, pla...
Portrait of sen...
Medical assista...
Senior Male Pha...
Experienced sen...
Young woman sci...
Scientist work ...
A divine scient...
Always wear a s...
Focused senior ...
Experienced sen...
Nutrition exper...
hospital health...
shot of a matur...
Senior male res...
A senior male p...
Image of data p...
Senior chemistr...
Scientist man, ...
Scientists are ...
Image of a coro...
Senior male res...
Focused senior ...
portrait of a s...
Angry chemist ...
Science, resear...
Test tube, plan...
Scientist in Me...
Senior male sci...
Close-up of a s...